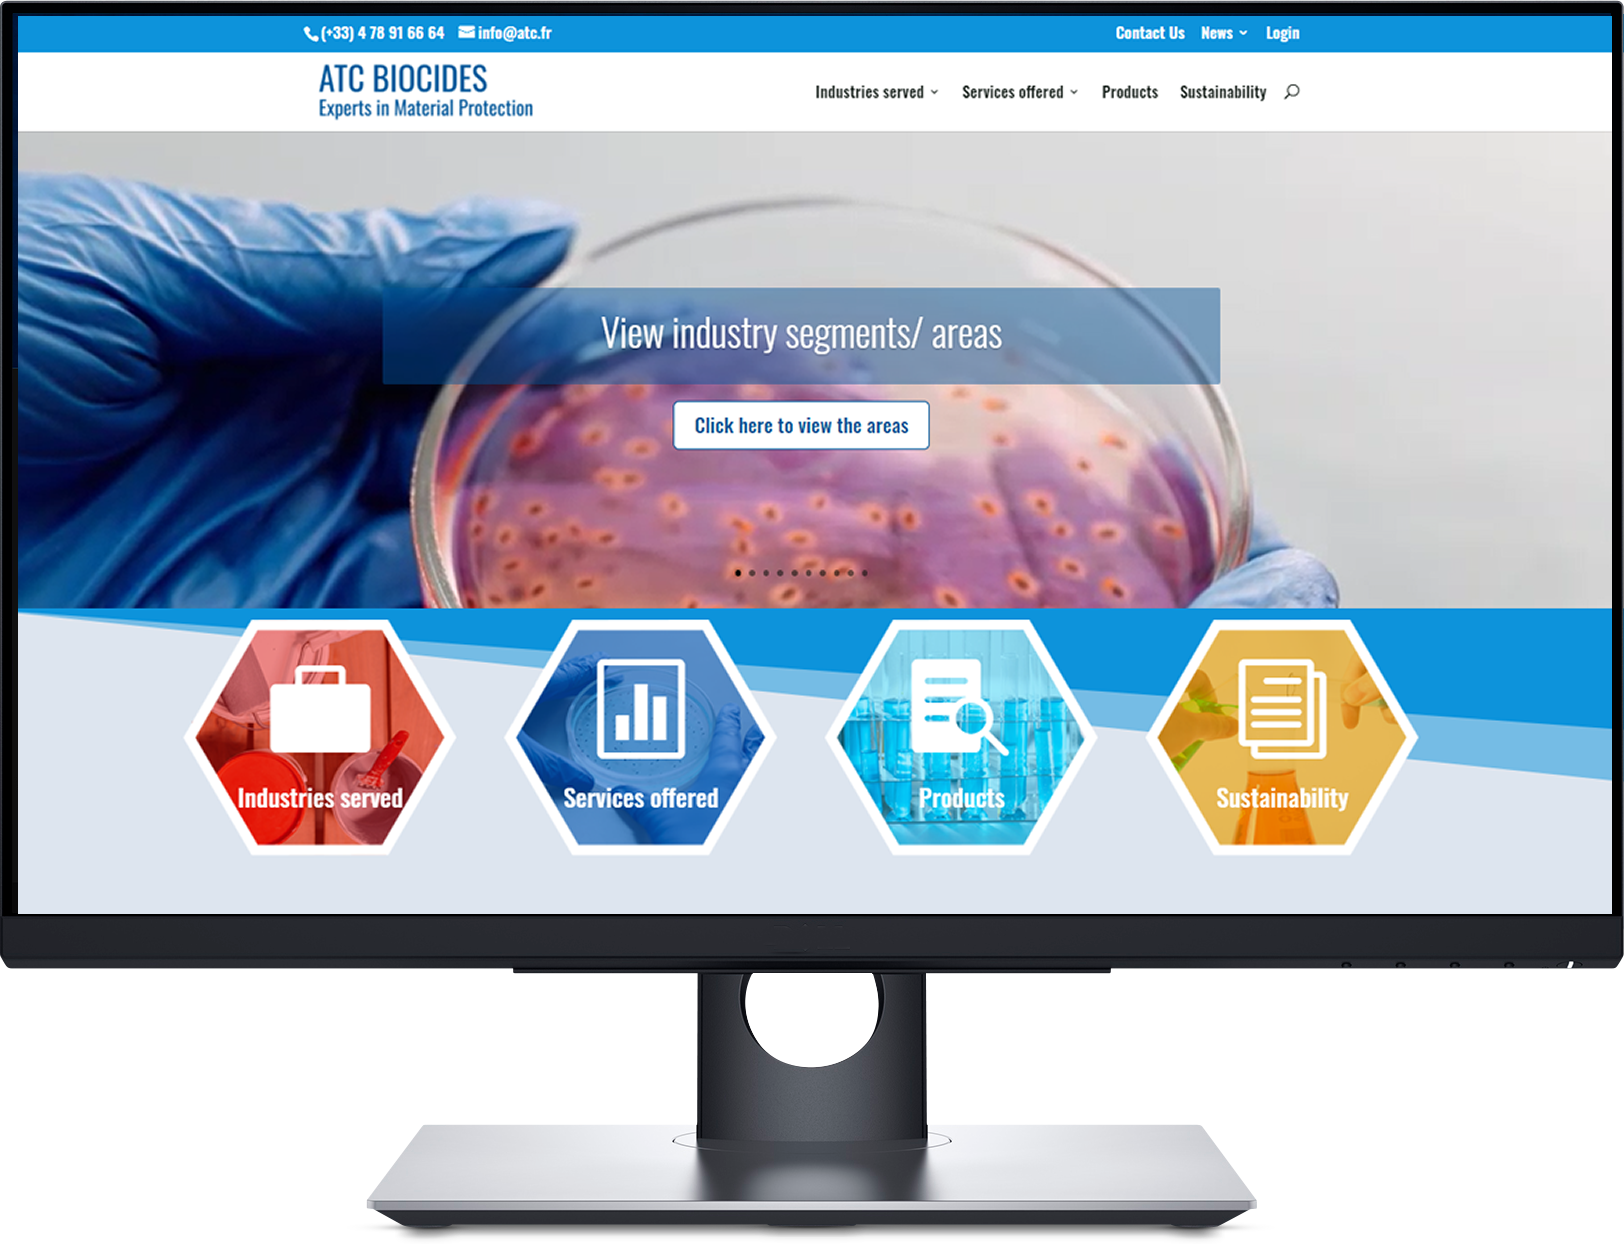

Portfolio
The key to a great website is consistency and standardised design
Take a look at some of the features we can deploy to bring your website to life

Settrington

Hipswell Primary School

Welburn Primary School

Bilsdale

Holy Family School

Husthwaite Primary School

GoLocal

Harrogate and Rural Alliance